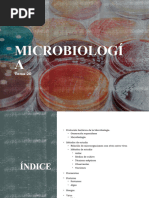

INICIO
ESQUEMA
RECURSOS
INTERNET
BIOLOGA Y GEOLOGA 3. ESO
Sistemas nervioso y hormonal
ACTIVIDAD
LECTURA INICIAL
ESQUEMA
RECURSOS
INTERNET
ACTIVIDAD
ANTERIOR
SALIR
�INICIO
ESQUEMA
RECURSOS
Lectura inicial
Ramn y Cajal
INTERNET
BIOLOGA Y GEOLOGA 3. ESO
Sistemas nervioso y hormonal
ACTIVIDAD
Hasta finales del siglo XIX se saba poco sobre la estructura y
funcionamiento del sistema nervioso. Los llamados reticulistas crean
que el tejido nervioso estaba formado por miles de millones de clulas,
unidas unas a otras formando una enmaraada red, con multitud de
prolongaciones que dificultaban su estudio.
En 1875, Camillo Golgi dio con un mtodo mediante el cual, al azar, solo
una porcin muy pequea de clulas se tean a la vez y lo hacan por
entero. En lugar de aquella maraa de clulas inservible, la tincin de
Golgi permita observar al microscopio solo unas cuantas clulas
nerviosas, diferencindolas de los tejidos que se encontraban a su
alrededor. Esta fue una tcnica revolucionaria, ya que permiti ver por
primera vez estructuras nerviosas desconocidas hasta el momento.
Sin embargo, el descubrimiento de la estructura del sistema nervioso se
debe al espaol Santiago Ramn y Cajal, que, mejorando la tincin,
revel que este sistema estaba constituido por clulas separadas, bien
definidas y que se comunicaban entre s a travs de espacios vacos. El
investigador espaol decidi enfrentarse con su teora anti-reticulista a
los grandes cientficos de la poca, encontrando en Golgi su ms firme
detractor.
Los trabajos de Ramn y Cajal sobre el sistema nervioso se vieron
refrendados con la concesin, en 1906, del premio Nobel de Fisiologa y
Medicina, galardn que comparti con Golgi. Sin embargo, este ltimo
persisti en su teora y se neg a respaldar
las investigaciones de Ramn y Cajal.
Dibujos del tejido nervioso
realizados por Ramn y Cajal
ANTERIOR
SALIR
�INICIO
ESQUEMA
RECURSOS
INTERNET
BIOLOGA Y GEOLOGA 3. ESO
Sistemas nervioso y hormonal
ACTIVIDAD
Esquema de contenidos
Los sistemas de coordinacin
Caractersticas
El sistema nervioso
El sistema endocrino
Componentes
Las neuronas
Las clulas gliales
Componentes
Caractersticas
Tipos de glndulas
Organizacin
Sistema nervioso central
Sistema nervioso perifrico
Funcionamiento
Caractersticas
Funcionamiento
Actos voluntarios y actos re
flejos
Trastornos
Enfermedades
Trastornos
Fsicos u orgnicos
Psquicos
Hbitos saludables
La conducta humana
Caractersticas
INICIO
ANTERIOR
SALIR
�INICIO
ESQUEMA
RECURSOS
INTERNET
BIOLOGA Y GEOLOGA 3. ESO
Sistemas nervioso y hormonal
ACTIVIDAD
Recursos para la explicacin de la unidad
Caractersticas de
los
sistemas
de
coordinacin
Las neuronas
El control
hormonal
Las clulas
gliales
El sistema
nervioso central
El sistema
nervioso
perifrico
Actos
voluntarios
y actos
reflejos
Trastornos fsicos
Trastornos
psquicos
Hbitos
saludables
Caractersticas
del sistema
endocrino
Tipos de
glndulas
Funcionamiento
del sistema
hormonal
Enfermedades del
sistema
endocrino
La conducta
humana
Enlaces
Actividades
INICIO
ANTERIOR
SALIR
�INICIO
ESQUEMA
RECURSOS
INTERNET
BIOLOGA Y GEOLOGA 3. ESO
Sistemas nervioso y hormonal
ACTIVIDAD
Caractersticas de los sistemas de coordinacin
Elementos que intervienen en la coordinacin
Informacin
del medio
Receptor
Estmulo
Sistemas de coordinacin
- Sistema nervioso
- Sistema endocrino
Centro
nervioso
Respuesta
Efector
msculo
Efector
glndula
Respuesta
motora
Respuesta
secretora
Respuesta
Funcin de relacin
ANTERIOR
SALIR
�INICIO
ESQUEMA
RECURSOS
INTERNET
BIOLOGA Y GEOLOGA 3. ESO
Sistemas nervioso y hormonal
ACTIVIDAD
Las neuronas
Axn
Cuerpo celular
Neurona
presinptica
Neurotransmisores
Espacio
sinptico
Dendritas
Neurona postsinptica
ANTERIOR
SALIR
�INICIO
ESQUEMA
RECURSOS
INTERNET
BIOLOGA Y GEOLOGA 3. ESO
Sistemas nervioso y hormonal
ACTIVIDAD
El control hormonal
ABRIR
ANTERIOR
SALIR
�INICIO
ESQUEMA
RECURSOS
INTERNET
BIOLOGA Y GEOLOGA 3. ESO
Sistemas nervioso y hormonal
ACTIVIDAD
Las clulas gliales
Clula de Schwann
Vaina de mielina
Nutrientes
Astrocito
ANTERIOR
SALIR
�INICIO
ESQUEMA
RECURSOS
INTERNET
BIOLOGA Y GEOLOGA 3. ESO
Sistemas nervioso y hormonal
ACTIVIDAD
El sistema nervioso central
Encfalo
Mdula
espinal
Nervios
espinales
Mdula espinal
Vrtebras
ANTERIOR
LAS LUPAS
AMPLAN
LAS IMGENES
SALIR
�INICIO
ESQUEMA
RECURSOS
INTERNET
BIOLOGA Y GEOLOGA 3. ESO
Sistemas nervioso y hormonal
ACTIVIDAD
El sistema nervioso central
Encfalo
Circunvoluciones
Mdula
espinal
Cerebro
Bulbo raqudeo
Cerebelo
VOLVER
ANTERIOR
SALIR
�INICIO
ESQUEMA
RECURSOS
INTERNET
BIOLOGA Y GEOLOGA 3. ESO
Sistemas nervioso y hormonal
ACTIVIDAD
El sistema nervioso central
Encfalo
Sustancia gris
Mdula
espinal
Sustancia blanca
VOLVER
ANTERIOR
SALIR
�INICIO
ESQUEMA
RECURSOS
INTERNET
BIOLOGA Y GEOLOGA 3. ESO
Sistemas nervioso y hormonal
ACTIVIDAD
El sistema nervioso perifrico
Nervios
craneales
Nervios
espinales
Sistema nervioso
perifrico
Sistema nervioso
somtico
Sistema nervioso
vegetativo/autnomo
Movimiento corporal
(control voluntario)
Funciones bsicas
(control involuntario)
Nervios sensitivos
Segn
su
funcin
informacin
Nervios motores
ANTERIOR
SALIR
�INICIO
ESQUEMA
RECURSOS
INTERNET
BIOLOGA Y GEOLOGA 3. ESO
Sistemas nervioso y hormonal
ACTIVIDAD
Actos voluntarios y actos reflejos
Cerebro
PULSA PARA VER LA
RESPUESTA VOLUNTARIA
DEL SISTEMA NERVIOSO
Receptor
Estmulo
Sonido
Nervio
sensitivo
PULSA PARA VER LA
RESPUESTA INVOLUNTARIA
DEL SISTEMA NERVIOSO
ANTERIOR
SALIR
�INICIO
ESQUEMA
RECURSOS
INTERNET
BIOLOGA Y GEOLOGA 3. ESO
Sistemas nervioso y hormonal
ACTIVIDAD
VOLVER
Actos voluntarios y actos reflejos
Respuesta
Cerebro
Efector
Nervio
motor
Impulso
nervioso
ANTERIOR
SALIR
�INICIO
ESQUEMA
RECURSOS
INTERNET
BIOLOGA Y GEOLOGA 3. ESO
Sistemas nervioso y hormonal
ACTIVIDAD
VOLVER
Actos voluntarios y actos reflejos
Neurona sensitiva
Estmulo
Receptor
Glndula lacrimal
Neurona
de asociacin
Neurona motora
Efector
Llanto
ANTERIOR
SALIR
�INICIO
ESQUEMA
RECURSOS
INTERNET
BIOLOGA Y GEOLOGA 3. ESO
Sistemas nervioso y hormonal
ACTIVIDAD
Trastornos fsicos que afectan a la salud mental
Enfermedades infecciosas
Golpes
Poliomielitis
Lesiones en la mdula
Meningitis
Paraplejia
Tetraplejia
Obstruccin o rotura de arterias
cerebrales
Enfermedades
neurodegenerativas
Muerte de neuronas
Alzheimer
Parkinson
ANTERIOR
SALIR
�INICIO
ESQUEMA
RECURSOS
INTERNET
BIOLOGA Y GEOLOGA 3. ESO
Sistemas nervioso y hormonal
ACTIVIDAD
Trastornos psquicos que afectan a la salud mental
Hiperactividad
Esquizofrenia
Depresin
Ansiedad
Trastorno
Obsesivo - compulsivo
ANTERIOR
SALIR
�INICIO
ESQUEMA
RECURSOS
INTERNET
BIOLOGA Y GEOLOGA 3. ESO
Sistemas nervioso y hormonal
ACTIVIDAD
Hbitos saludables del sistema nervioso
Mantener una
vida ordenada
Llevar una alimentacin
equilibrada
Evitar situaciones peligrosas
Hacer ejercicio fsico
Tomar medidas
de proteccin
No consumir tabaco,
alcohol o drogas
Realizar actividades
intelectuales
ANTERIOR
SALIR
�INICIO
ESQUEMA
RECURSOS
INTERNET
BIOLOGA Y GEOLOGA 3. ESO
Sistemas nervioso y hormonal
ACTIVIDAD
Caractersticas del sistema endocrino
Hipotlamo e hipfisis
Tiroides y paratiroides
Cpsulas suprarrenales
Pncreas
Ovarios
Testculos
LAS LUPAS
AMPLAN
LAS IMGENES
ANTERIOR
SALIR
�INICIO
ESQUEMA
RECURSOS
INTERNET
BIOLOGA Y GEOLOGA 3. ESO
Sistemas nervioso y hormonal
ACTIVIDAD
Caractersticas del sistema endocrino
Hipotlamo e hipfisis
Hipotlamo
Hipfisis
VOLVER
ANTERIOR
SALIR
�INICIO
ESQUEMA
RECURSOS
INTERNET
BIOLOGA Y GEOLOGA 3. ESO
Sistemas nervioso y hormonal
ACTIVIDAD
Caractersticas del sistema endocrino
Tiroides y paratiroides
Tiroides
Paratiroides
VOLVER
ANTERIOR
SALIR
�INICIO
ESQUEMA
RECURSOS
INTERNET
BIOLOGA Y GEOLOGA 3. ESO
Sistemas nervioso y hormonal
ACTIVIDAD
Caractersticas del sistema endocrino
Cpsulas suprarrenales
VOLVER
ANTERIOR
SALIR
�INICIO
ESQUEMA
RECURSOS
INTERNET
BIOLOGA Y GEOLOGA 3. ESO
Sistemas nervioso y hormonal
ACTIVIDAD
Caractersticas del sistema endocrino
Pncreas
VOLVER
ANTERIOR
SALIR
�INICIO
ESQUEMA
RECURSOS
INTERNET
BIOLOGA Y GEOLOGA 3. ESO
Sistemas nervioso y hormonal
ACTIVIDAD
Caractersticas del sistema endocrino
Ovarios
VOLVER
ANTERIOR
SALIR
�INICIO
ESQUEMA
RECURSOS
INTERNET
BIOLOGA Y GEOLOGA 3. ESO
Sistemas nervioso y hormonal
ACTIVIDAD
Caractersticas del sistema endocrino
Testculos
VOLVER
ANTERIOR
SALIR
�INICIO
ESQUEMA
RECURSOS
INTERNET
BIOLOGA Y GEOLOGA 3. ESO
Sistemas nervioso y hormonal
ACTIVIDAD
Tipos de glndulas
Glndulas endocrinas
Hipotlamo e hipfisis
Testculos
Sintetizan hormonas
Vierten a sangre
Tiroides
y
paratiroides
Ovarios
Cpsulas
suprarrenales
Glndulas exocrinas
NO PERTENECEN AL
SISTEMA ENDOCRINO
Vierten al exterior
o a cavidades internas
Glndulas
lacrimales
Glndulas sudorparas
Glndulas salivales
Glndulas mixtas
Son endocrinas y exocrinas al mismo tiempo
Pncreas
ANTERIOR
SALIR
�INICIO
ESQUEMA
RECURSOS
INTERNET
BIOLOGA Y GEOLOGA 3. ESO
Sistemas nervioso y hormonal
ACTIVIDAD
Funcionamiento del sistema hormonal
Glndula
suprarrenal
Estmulo
Hipotlamo
Retroalimentacin
Hipfisis
Glndula
Niveles
altos
en sangre
Hormona
VER PRODUCCIN
DE INSULINA
Adrenalina
rgano o
clula diana
Respuesta
Estimulacin
Inhibicin
Msculos
ANTERIOR
SALIR
�INICIO
ESQUEMA
RECURSOS
INTERNET
BIOLOGA Y GEOLOGA 3. ESO
Sistemas nervioso y hormonal
ACTIVIDAD
VOLVER
Funcionamiento del sistema hormonal
Niveles altos
de glucosa
Niveles bajos
de glucosa
Estmulo
Hormona
Estmulo
Glndula
Glndula
Pncreas
Pncreas
Insulina
Sangre
Respuesta
Hgado
Glucagn
Hormona
Hgado
Disminuye el
nivel de glucosa
en sangre
Clulas musculares
Clulas
musculares
Respuesta
Aumenta el nivel
de glucosa en
sangre
ANTERIOR
Sangre
SALIR
�INICIO
ESQUEMA
RECURSOS
INTERNET
BIOLOGA Y GEOLOGA 3. ESO
Sistemas nervioso y hormonal
ACTIVIDAD
Enfermedades del sistema endocrino
Enfermedades del tiroides
Diabetes
Hipertiroidismo
Diabetes
Tipo 1
Carencia de clulas
que producen insulina
Diabetes
Tipo 2
Aumento del
metabolismo
Hipotiroidismo
Enlentecimiento
del metabolismo
Las clulas no usan la
insulina adecuadamente
Enanismo
y gigantismo
Islotes de Langerhans
Clula
Problemas en la produccin
de la hormona del crecimiento
durante el desarrollo
ANTERIOR
SALIR
�INICIO
ESQUEMA
RECURSOS
INTERNET
BIOLOGA Y GEOLOGA 3. ESO
Sistemas nervioso y hormonal
ACTIVIDAD
La conducta humana
Ambiente social
Conducta estereotipada
Ambiente cultural
Conducta adquirida
Herencia gentica
ANTERIOR
SALIR
�INICIO
ESQUEMA
RECURSOS
INTERNET
BIOLOGA Y GEOLOGA 3. ESO
Sistemas nervioso y hormonal
ACTIVIDAD
Enlaces de inters
El sistema nervioso
El sistema endocrino
IR A ESTA WEB
IR A ESTA WEB
INICIO
ANTERIOR
SALIR
�INICIO
ESQUEMA
RECURSOS
INTERNET
BIOLOGA Y GEOLOGA 3. ESO
Sistemas nervioso y hormonal
ACTIVIDAD
ABRIR
INICIO
VER ACTIVIDAD 2
ANTERIOR
SALIR
�INICIO
ESQUEMA
RECURSOS
INTERNET
BIOLOGA Y GEOLOGA 3. ESO
Sistemas nervioso y hormonal
ACTIVIDAD
VER ACTIVIDAD 3
INICIO
ANTERIOR
SALIR
�INICIO
ESQUEMA
RECURSOS
INTERNET
BIOLOGA Y GEOLOGA 3. ESO
Sistemas nervioso y hormonal
ACTIVIDAD
INICIO
ANTERIOR
SALIR